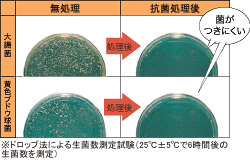

室内のきれいに 室内空気環境
空気のよごれは、カビやダニの原因となります。
健康に、そして安心して暮らせる空気環境に、
アイフルホームはこだわります。




天井裏につけた熱交換気ユニットやダクトで換気を行なうシステムです。熱交換タイプなので冷暖房時の熱ロスを防ぎ、CO2排出量も抑えます。また、PM2.5に対応する微小粒子用フィルターを搭載。外気の汚れをきれいにして室内へ取り込みます。



フローリング&タタミ
ハイハイが大好きな赤ちゃんにとって安全で、快適な床材
いつまでも美しい色合いを保つフローリングは、傷が付きにくい3層のコーティングを表面に施し、はいはいする赤ちゃんにとっても安心な、小さな菌の増殖を抑える抗菌仕様です。
高機能バリアフリー新畳の特徴
- ダニ、カビが発生しにくい
- 優れた遮音性
- F☆☆☆☆の低ホルムアルデヒド放散量
- 表替えの出来る本格畳仕様
- 熱や吸湿・乾燥に伴う寸法変化を抑制
- 畳としての適度な固さ